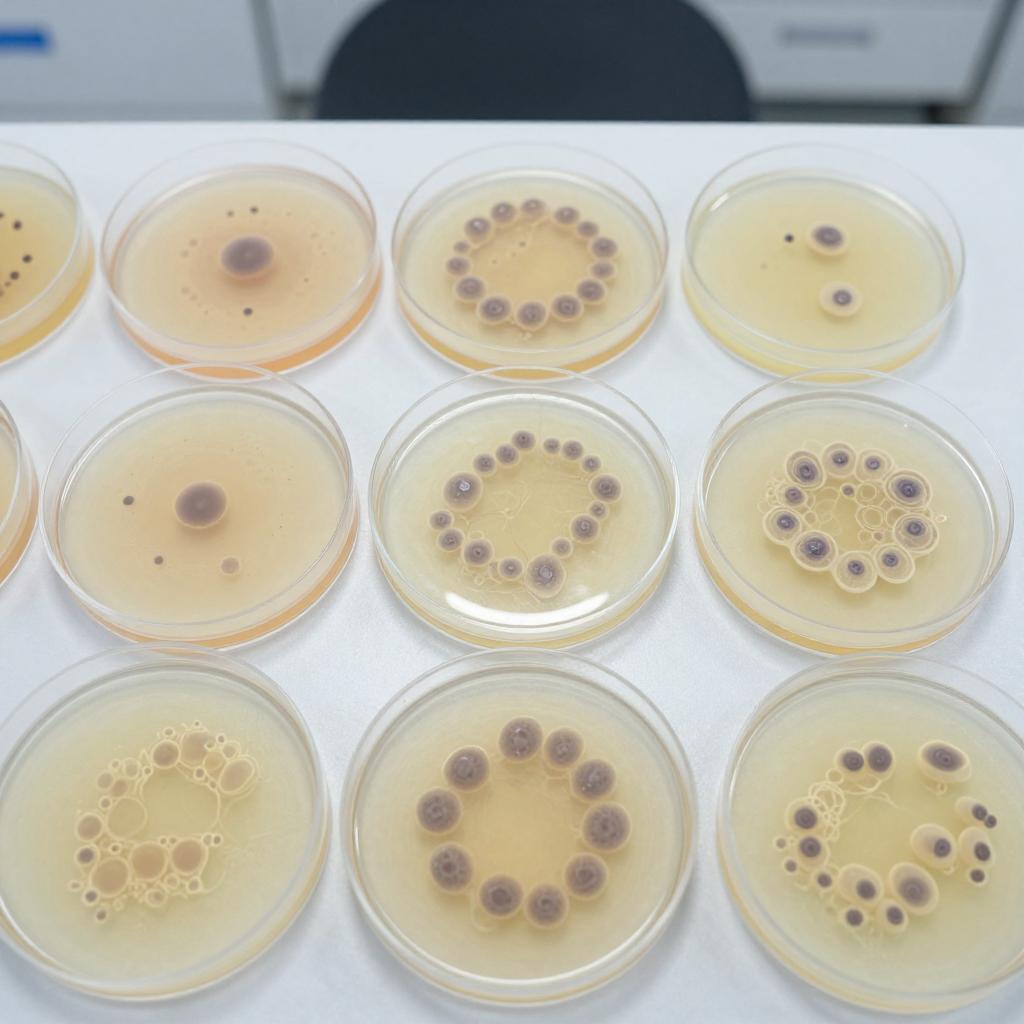
用干细胞制作人类胚胎模型为时不远？ 呼吁从伦理层面考量相关研究第二张图

在实验室内利用干细胞制作小鼠和人类胚胎模型正在快速向前发展,与此同时也带来了深刻的法律问题和伦理问题。鉴于此,英国《自然》杂志近日发表了一篇评论文章,呼吁国际社会展开讨论,为这一快速发展的研究领域指明方向。
在评论中,包括荷兰胡布勒支研究所、美国杰克逊实验室的科学家们都认为,必须对人类干细胞源胚胎模型的法律地位以及这种研究的应用进行公开透明的讨论,以便帮助各个国家制定相应的政策法规。他们写道:“与公众进行有效的沟通,是确保审慎推进前景可观研究方法的关键。”
在过去的18个月里,研究人员开发了包含类似卵黄囊和胎盘组织的小鼠模型。评论文章指出,预计距离使用人体干细胞制作类似的人类模型也为时不远了。这类模型有望改进避孕药,提高体外受精(IVF)的有效性和安全性,促进发育障碍的防治。

文章中,科学家们提出了数个需要公开加以讨论的问题,包括现在或未来是否应将实验室中的胚胎样实体视作人类胚胎,以及应该如何设置培养完整人类胚胎的限度等。他们督促资助机构以及科学、医学共同体带头展开讨论。
能否把胚胎样实体视作人类胚胎一直存在巨大争议。部分学者认为,人类胚胎虽有潜力发育成为完整的人,但具有潜能与事实存在的人仍是有区别的;而反对的观点认为,人类的胚胎自受精伊始,就应视作具有发育成人的能力。
此次发表的文章属于《自然》期刊内的评论,而非经过同行评议的《自然》研究论文,这一类评论文章是关于科学研究及其影响的权威性时评。
早在上世纪80年代,英国就已经有针对是否应该允许人类胚胎模型出现的讨论。从医学角度讲,人类胚胎体外研究无疑会使人类受益,但从伦理角度,胚胎是否就等同于事实存在的人?是否应该具有与其同样的道德地位?争论双方无法达成一致意见。亦因此,才有了“14天期限”原则的诞生,即不得在体外培养人类胚胎超过14天。这一重要规则也一直延续至今。而今,胚胎培养技术上不断出现突破,呼唤着人们对既有框架的重新考虑,以期能找到一个符合科学利益、社会利益以及潜在医疗利益的最佳方案。
未经允许不得转载:医械工坊资讯 » 用干细胞制作人类胚胎模型为时不远? 呼吁从伦理层面考量相关研究
